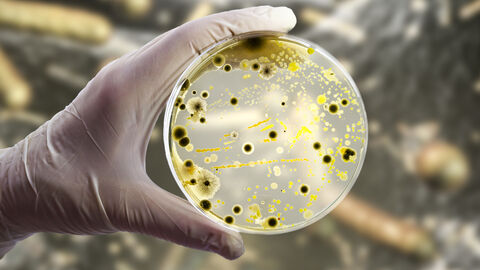
Bakterien und Schimmelpilze sammeln sich in einer Petrischale.

5 Millionen Beschäftigte kommen täglich in Deutschland mit biologischen Arbeitsstoffen in Kontakt.
Biologische Arbeitsstoffe bzw. Biostoffe (Bakterien, Viren, Pilze, Parasiten, Prionen) treten z.B. in der Biotechnologie, in der medizinischen Forschung, der Nahrungsmittelproduktion, der Land- und Forstwirtschaft, der Abfall- und Abwasserwirtschaft, im Gesundheitswesen und in Kindertagesstätten auf. Ohne geeignete Schutzmaßnahmen kann der Umgang zu Infektionen, Allergien oder Atemwegserkrankungen führen.
Die Biostoffverordnung teilt Bakterien, Pilze, Viren und Parasiten etc. mit steigender Gefährlichkeit in Risikogruppen von 1 bis 4 ein. Darüber hinaus wird zwischen gezielten und nicht gezielten Tätigkeiten unterschieden. Gezielte Tätigkeiten setzen u.a. voraus, dass die Arbeiten auf den Biologischen Arbeitsstoff ausgerichtet sind, wie bspw. in der Forschung, der Biotechnologie oder speziellen Infektionsstationen. Um nicht gezielte Tätigkeiten handelt es sich, wenn mit möglicherweise kranken Menschen oder Tieren bzw. biologisch verunreinigten Materialien umgegangen wird, wie im Gesundheitswesen, in Betreuungseinrichtungen, in der Abfall- und Abwasserbranche, der Forst- und Landwirtschaft und in der Lebensmittelindustrie. Entsprechend der Risikogruppe bzw. der Gefährdung durch die Art der Tätigkeit muss der Arbeitgeber Schutzmaßnahmen festlegen. Sie werden, abhängig von ihrer Schutzfunktion, in Schutzstufen von 1 bis 4 eingeteilt.
Tätigkeiten unter Schutzstufe 3 und 4 in Laboratorien, in der Versuchstierhaltung oder in der Biotechnologie sowie unter Schutzstufe 4 in Einrichtungen des Gesundheitsdienstes bedürfen vor Aufnahme der Tätigkeit einer Erlaubnis (§15 BioStoffV) des zuständigen Regierungspräsidiums.
Anzeigepflichtig (§16 BioStoffV) beim zuständigen Regierungspräsidium sind:
1. die erstmalige Aufnahme
a) gezielter Tätigkeiten mit Biostoffen der Risikogruppe 2 oder Risikogruppe 3**
b) nicht gezielter Tätigkeiten der Schutzstufe 2 mit Biostoffen der Risikogruppe 3 und 3**, sofern die Tätigkeiten auf diese Biostoffe ausgerichtet sind und regelmäßig durchgeführt werden sollen,
in Laboratorien, in der Versuchstierhaltung und in der Biotechnologie.
2. jede Änderung der erlaubten oder angezeigten Tätigkeiten, wenn diese für die Sicherheit und den Gesundheitsschutz bedeutsam sind, zum Beispiel Tätigkeiten, die darauf abzielen, die Virulenz des Biostoffs zu erhöhen oder die Aufnahme von Tätigkeiten mit weiteren Biostoffen der Risikogruppe 3 oder 4,
3. die Inbetriebnahme einer Patientenstation der Schutzstufe 4 bei Aufnahme einer infizierten Patientin oder eines infizierten Patienten sowie die anschließende Außerbetriebnahme,
4. das Einstellen einer nach § 15 erlaubnispflichtigen Tätigkeit.
Mehr Information zumsicheren Umgang mit biologischen Arbeitsstoffen finden Sie auch im Portal Arbeitswelt Hessen.Öffnet sich in einem neuen Fenster
Wenn Sie nach Informationen zu Arbeiten mit gentechnisch veränderten Organismen suchen, finden Sie diese bei unserem Dezernat für Gentechnik.